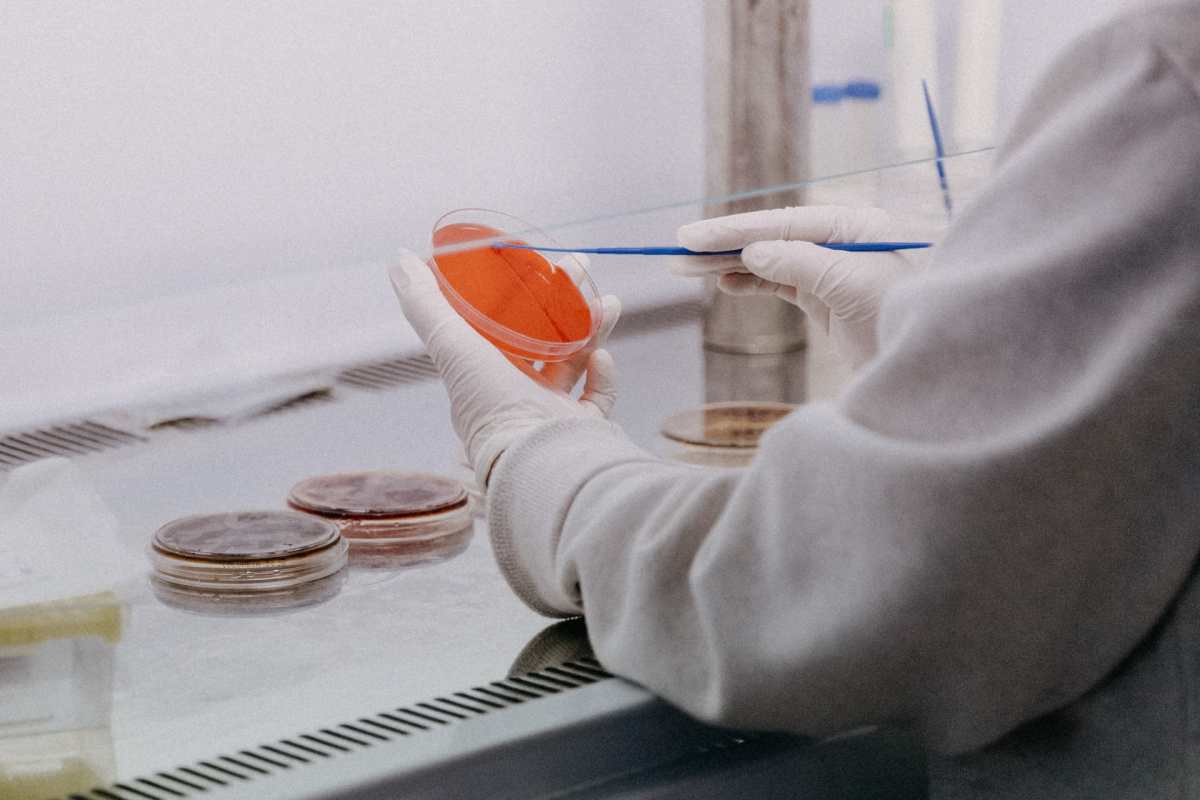

20 de mayo de 2022 - 22:00h
Viruela del mono: cómo se trasmite, cuáles son los síntomas y qué hacer para evitar contagiarte

18 de mayo de 2022 - 19:31h
Viruela del mono: en qué consiste la extraña enfermedad que está afectando a EE. UU. y varios países de Europa

8 de agosto de 2021 - 9:10h
Los niños mexicanos que fueron utilizados como “neveras” de vacunas para salvar al mundo de la viruela
17 de julio de 2021 - 15:56h
Primer caso de viruela de mono en Texas: los CDC dicen que riesgo de contagio podría ser nulo

6 de diciembre de 2019 - 6:53h
Qué es la “viruela de los monos”, la rara infección que descubrieron en un paciente en Reino Unido

23 de julio de 2018 - 17:23h





